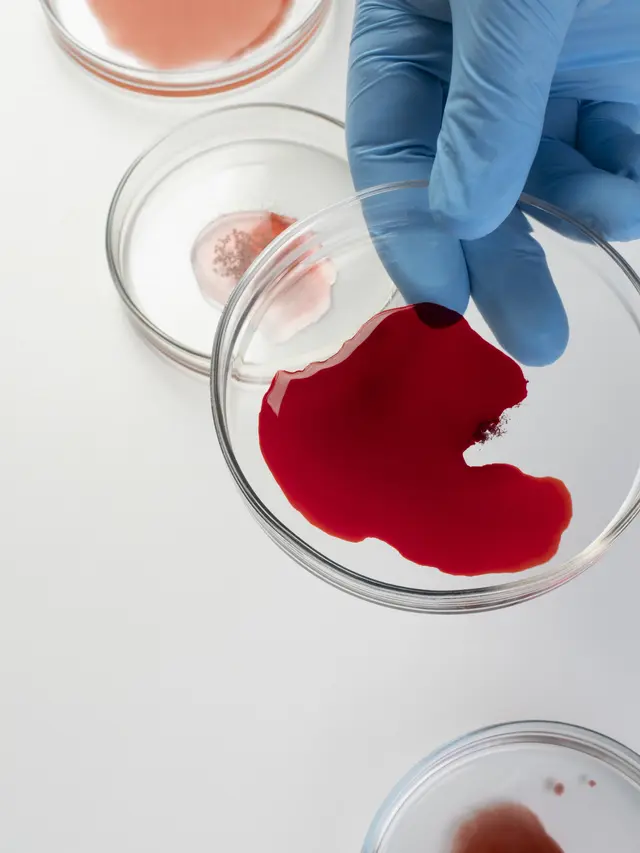

NewsRepublik.com, Kesehatan – Selama ini, masyarakat umum mengenal sistem golongan darah yang terbagi dalam empat tipe utama: A, B, AB, dan O—masing-masing dengan Rhesus positif atau negatif. Namun, dunia medis kini dihadapkan pada temuan luar biasa: golongan darah baru yang sangat langka dan belum pernah tercatat sebelumnya, yakni Gwada Negatif.
Penemuan menakjubkan ini secara resmi menambah jumlah sistem golongan darah manusia menjadi 48, menandai tonggak penting dalam sejarah transfusi darah dan kedokteran modern. Gwada Negatif ditemukan berkat riset mendalam selama hampir 15 tahun yang dilakukan oleh tim ilmuwan dari Lembaga Darah Prancis (French Blood Establishment/EFS).
Kasus Langka dari Guadeloupe
Kisah luar biasa ini bermula pada 2011 ketika seorang perempuan berusia 54 tahun asal Guadeloupe—wilayah Karibia yang berada di bawah administrasi Prancis—menjalani pemeriksaan medis rutin sebelum menjalani operasi di Paris. Dalam proses itu, tim medis menemukan antibodi misterius yang tidak sesuai dengan sistem golongan darah apa pun yang dikenal saat itu. Namun, keterbatasan teknologi kala itu membuat kasus ini belum dapat ditelusuri lebih lanjut.
Baru pada 2019, tim peneliti dari Lembaga Darah Prancis (EFS) kembali membuka berkas kasus tersebut. Mereka meminta sampel darah tambahan dan melakukan analisis genetika lengkap terhadap wanita itu. Hasilnya mencengangkan: ditemukan mutasi genetik ultra-langka yang diturunkan dari kedua orang tuanya dan menghasilkan jenis darah yang benar-benar baru.
“Ia adalah satu-satunya orang di dunia yang cocok dengan dirinya sendiri,” ujar Thierry Peyrard, pakar biologi dari EFS, dalam wawancaranya dengan Agence France-Presse (AFP).
Golongan darah baru itu kemudian dinamai “Gwada Negatif”, terinspirasi dari pelafalan fonetik “Guadeloupe”. Nama tersebut dipilih karena mudah diucapkan dalam berbagai bahasa dan kini mulai dikenal luas di kalangan ilmuwan hematologi.
Mengapa Penemuan Gwada Negatif Penting?
Penemuan golongan darah Gwada Negatif bukan sekadar penambahan daftar dalam sistem klasifikasi, melainkan terobosan besar dalam dunia kedokteran transfusi. Dalam pernyataan resminya, Lembaga Darah Prancis (EFS) menegaskan bahwa “Menemukan golongan darah baru berarti membuka peluang perawatan yang lebih tepat dan aman bagi pasien dengan tipe darah langka.”
Hal ini sangat krusial mengingat transfusi darah bukan hanya soal kecocokan ABO dan rhesus, tetapi juga sistem antigen lain yang bisa memicu reaksi imun berbahaya jika tidak dikenali. CDC mencatat bahwa lebih dari 14 juta unit darah ditransfusikan setiap tahun hanya di Amerika Serikat. Tanpa pemetaan yang akurat terhadap semua kemungkinan varian darah, pasien dengan kelainan langka seperti Gwada Negatif bisa menghadapi risiko serius, bahkan saat menjalani prosedur medis rutin.
Dengan memahami dan mendokumentasikan jenis darah baru seperti ini, dunia medis bisa menyusun protokol yang lebih personal dan mengurangi risiko transfusi yang keliru.
Sistem Golongan Darah: Lebih Rumit dari Sekadar A, B, O
Karl Landsteiner mungkin telah membuka pintu pemahaman soal golongan darah lewat sistem ABO, tapi itu baru permukaannya. Seiring kemajuan bioteknologi dan genetika, ilmuwan kini menyadari bahwa darah manusia dibedakan tidak hanya oleh 4 golongan utama dan faktor Rhesus, melainkan oleh ratusan antigen lain yang dapat menentukan kecocokan transfusi secara lebih presisi.
Menurut International Society of Blood Transfusion (ISBT), hingga kini terdapat sedikitnya 366 antigen yang diketahui menempel di permukaan sel darah merah. Variasi kecil pada satu atau dua antigen saja bisa menyebabkan seseorang memiliki tipe darah yang tergolong sangat langka, seperti Bombay Blood atau yang terbaru, Gwada Negatif.
Penemuan sistem baru bernama PigZ, tempat golongan Gwada Negatif berada, resmi menambah daftar sistem golongan darah dunia menjadi 48 sistem. Ini bukan hanya pencapaian akademik, tapi memiliki implikasi besar pada dunia klinis—mulai dari keamanan transfusi hingga penyimpanan darah untuk pasien dengan kebutuhan sangat spesifik.
Apakah Ada ‘Gwada’ Lain di Dunia?
Meski hingga kini hanya satu orang dari Guadeloupe yang diketahui memiliki golongan darah “Gwada Negatif,” para ilmuwan belum menutup kemungkinan adanya individu lain dengan mutasi serupa. Penelitian lanjutan sedang dijalankan oleh tim dari French Blood Establishment (EFS), termasuk pemeriksaan sampel darah dari wilayah-wilayah dengan keragaman genetik tinggi, seperti Karibia, Afrika Barat, dan Amerika Selatan.
Menurut Thierry Peyrard, penemuan langka ini mendorong komunitas ilmiah untuk meninjau ulang sistem klasifikasi darah yang selama ini digunakan. Dengan lebih banyak data, bukan tidak mungkin Gwada Negatif nantinya ditemukan pada individu lain yang selama ini tidak terdeteksi karena keterbatasan metode pengujian konvensional.